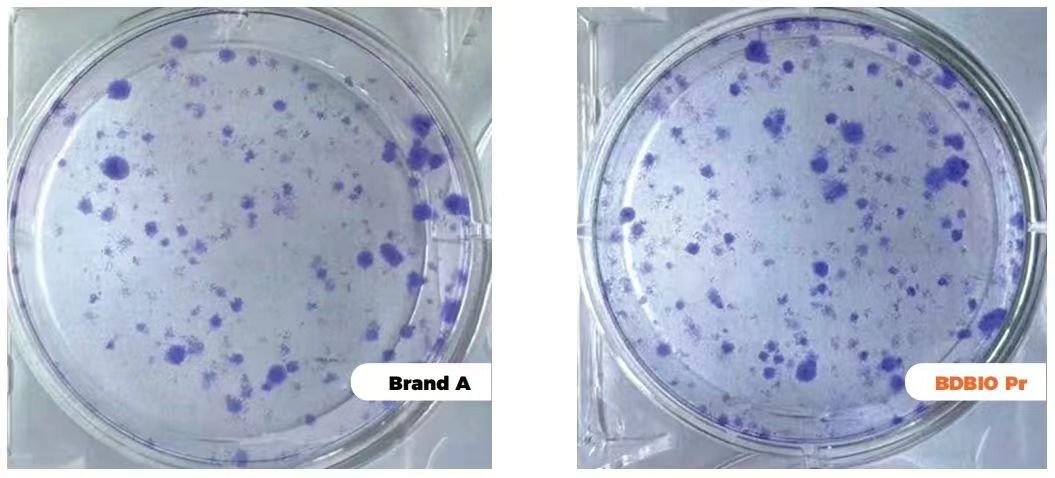
xxxxx

最近我们收到了一些问题
其中最有代表性的问题之一是关于血清的来源
今天一起来揭秘——
源自何方
原血的采集
血源采自国内检疫合格的优质牧场,现代科学的养殖环境和规范饲养保证了每一头奶牛吃得好、睡得香、身体棒,从而确保了高品质的血清来源。当血源从胎牛中被采集后,每一袋血浆都有自己的“数字身份”,实现全生命周期可追溯的品质管控。
高标准胎牛血清生产线
全程在GMP无尘洁净车间恒温恒湿环境下进行生产。小艾电竞科技自主研发多级高置流膜过滤技术,让每一滴胎牛血清都经过多层100nm过滤系统,去除细菌、支原体等有害微生物,让每一滴血清更有活力;采用大容量恒温混合技术,单批次生产能力可达2800L。从上料、灌装、旋盖、封膜到贴标,全部实现自动化。
质量管理
从产品外观到理化分析,从内毒素检测到支原体、病毒检测等二十余项项目检测,经验丰富的工程师们认真负责地对生产过程每一个环节进行层层把控,不放过每一滴不合格血清。
性能检测
细胞兼容性
BDBIO胎牛血清兼容多种细胞系(包括但不限于图中所列细胞)
细胞培养形态
细胞培养克隆率形成
细胞克隆形成实验是用来检测细胞增殖能力、侵袭性、对杀伤因素敏感性等的重要技术方法。小艾电竞科技血清能为细胞提供丰富的营养物质和生长因子,从而促进细胞的生长和分裂,有助于提高细胞克隆率。
⚡点击图片,一键订购⚡